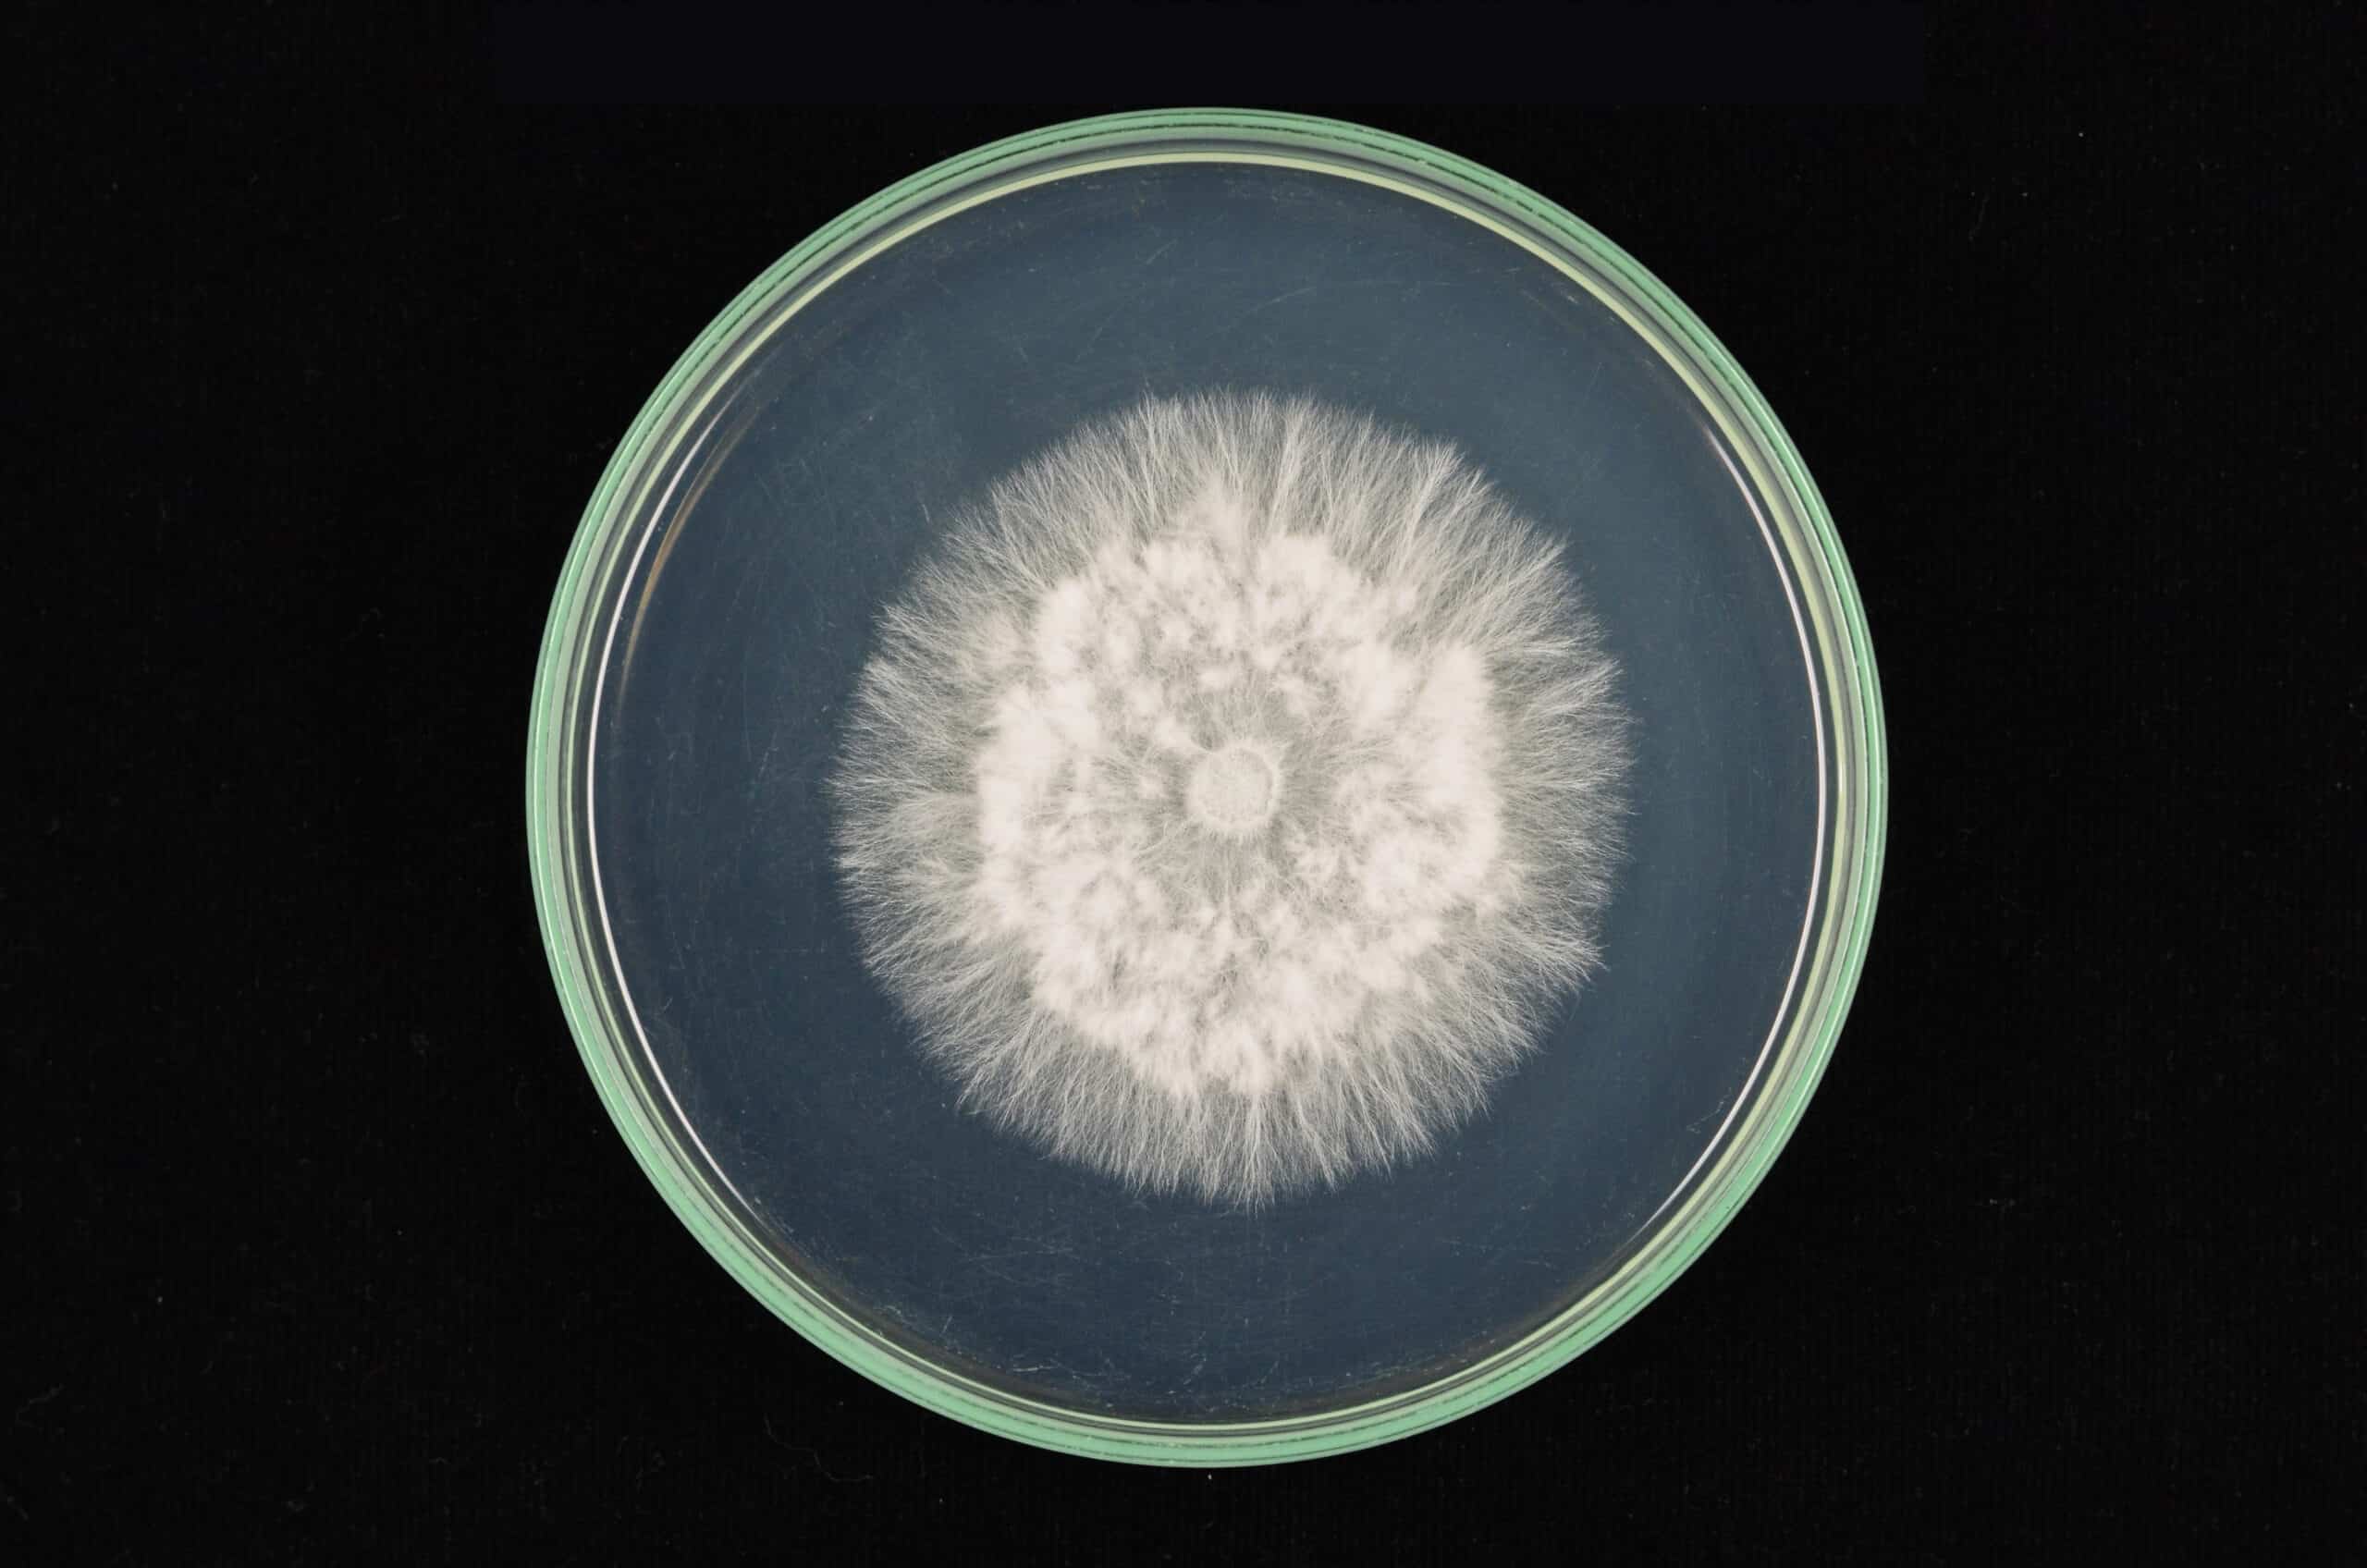

I tartufi alla psilocibina, spesso chiamati “tartufi magici”, sono un fenomeno naturale affascinante e un argomento di crescente interesse. In questo blog approfondiamo il mondo del tartufo alla psilocibina, da cosa è esattamente a come cresce.
I tartufi alla psilocibina sono le crescite sotterranee di alcuni funghi appartenenti alla famiglia delle Psilocybe. Questi tartufi contengono psilocibina, una sostanza psichedelica naturale. La psilocibina è nota per le sue proprietà psicoattive che, se ingerite, possono produrre una serie di effetti sia fisici che psicologici.
La psilocibina, il principio attivo di questi tartufi, viene convertita in psilocina nel corpo umano. Questa sostanza chimica è responsabile degli effetti psicoattivi, compresi i cambiamenti nella percezione, nell’umore e nei processi cognitivi.
I tartufi alla psilocibina sono fondamentalmente gli sclerozi del fungo. Questi sclerozi fungono da organi di stoccaggio, pieni di sostanze nutritive che il fungo utilizza per sopravvivere in condizioni avverse.
La coltivazione dei tartufi di psilocibina richiede condizioni specifiche:
I tartufi di psilocibina sono spesso utilizzati per scopi ricreativi e talvolta spirituali. Gli utenti descrivono spesso esperienze di profonda introspezione, euforia e allucinazioni visive. L’intensità dell’esperienza può variare a seconda della dose, dell’ambiente e della psicologia personale dell’utente.
È importante maneggiare i tartufi di psilocibina in modo responsabile. Ai principianti si consiglia di iniziare con una dose bassa e di osservare la reazione dell’organismo. È inoltre consigliabile utilizzare i tartufi in un ambiente sicuro e confortevole e preferibilmente con una persona sobria.
La ricerca scientifica sulla psilocibina è in aumento, soprattutto nel contesto della salute mentale. Gli studi suggeriscono che la psilocibina ha un potenziale nel trattamento di condizioni quali depressione, ansia e PTSD.



Valido dal 21 ottobre al 2 novembre 2025
Usa il codice qui sotto al checkout per ricevere il 15% di sconto sull’intero ordine.

